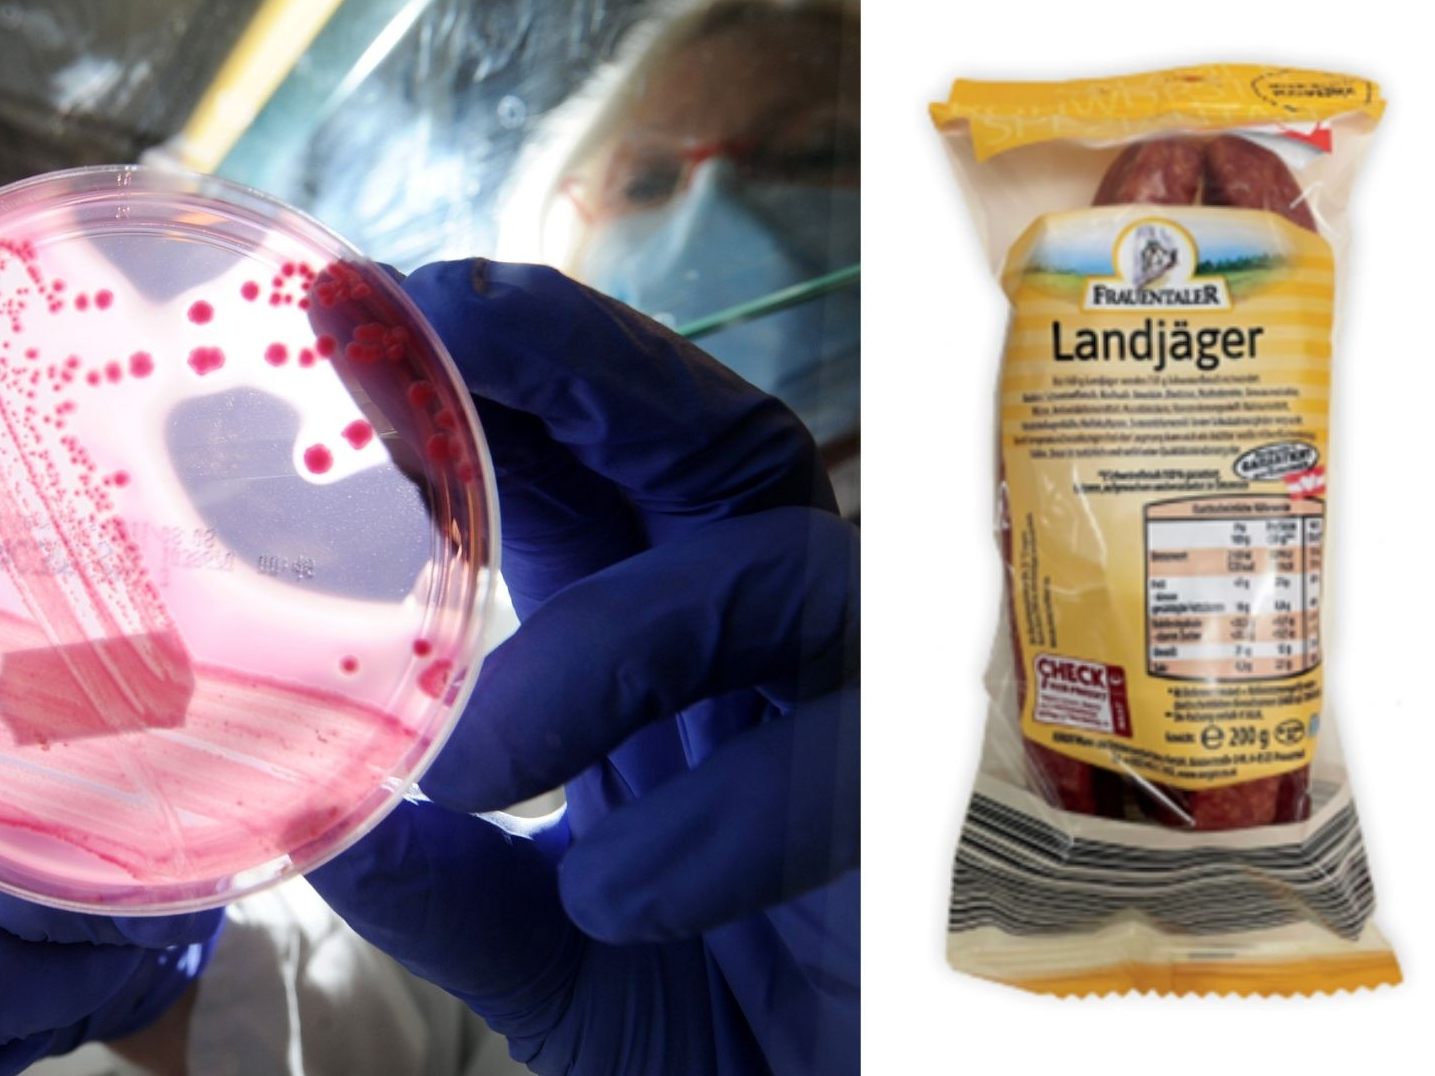
Der Erreger hatte 2011 in Österreich eine Lebensmittelkrise verursacht.

-
Videos, die von der Videoplattform der "Austria Presse Agentur" (APA) bereitgestellt werden.
-
Drittanbieter, über den Live Blogs der "Austria Presse Agentur" (APA) eingebettet sind.
-
Liveticker, Datencenter und Graphiken zu Sportereignissen oder Wahlen, die von der "Austria Presse Agentur" (APA) bereitgestellt werden.
-
Liveticker, Datencenter und Graphiken zu Sportereignissen oder Wahlen, die von der "Deutschen Presse Agentur" (DPA) bereitgestellt werden.
-
Verschiedene Widgets, wie z.B. Slider mit redaktionellem Inhalt, die vom Drittanbieter "Elfsight" auf unserer Website eingebunden sind.
-
Facebook-Posts, die auf unserer Seite eingebettet sind.
-
Videos, die von der Videoplattform "Glomex" bereitgestellt werden.
-
Artikelempfehlungen und Artikelverlinkungen, die über den Drittanbieter "iFramely" redaktionell erstellt und in Artikeln eingefügt werden.
-
Infographiken und Darstellungen zu verschiedenen Themen, die über den Drittanbieter "Infogram" erstellt wurden.
-
Posts von Instagram, die auf dieser Website eingebettet sind.
-
Drittanbieter, über den Live Blogs unserer eigenen Redaktion eingebettet sind.
-
Artikelempfehlungen, die auf dem Inhalt des Artikels, in dem sie eingebunden sind, basieren und vom Drittanbieter "Outbrain" bereitgestellt werden.
-
Podcasts, die über den Drittanbieter "Podigee" bereitgestellt werden.
-
Umfrage-Tool, welches vom Drittanbieter "Pinpoll" bereitgestellt und dessen Inhalte von unserer Redaktion gesteuert werden.
-
Infographiken, wie z.B. Darstellungen von Zeitachsen.
-
Liveticker und Datencenter zu Sportereignissen, meist mit Bezug zu Vorarlberg und dem "Ländlekicker".
-
Posts (Tweets) von Twitter, die auf dieser Website einbettet sind.
-
Videoempfehlungen, die vom Drittanbieter "Video Intelligence" bereitgestellt werden.
-
Videos, die von der Videoplattform "Vimeo" bereitgestellt werden.
-
Videos, die von der Videoplattform "Youtube" bereitgestellt werden.
-
Brightcove Videos.
-
Sonstiger redaktioneller Inhalt, der über Drittanbieter zur Verfügung gestellt wird.